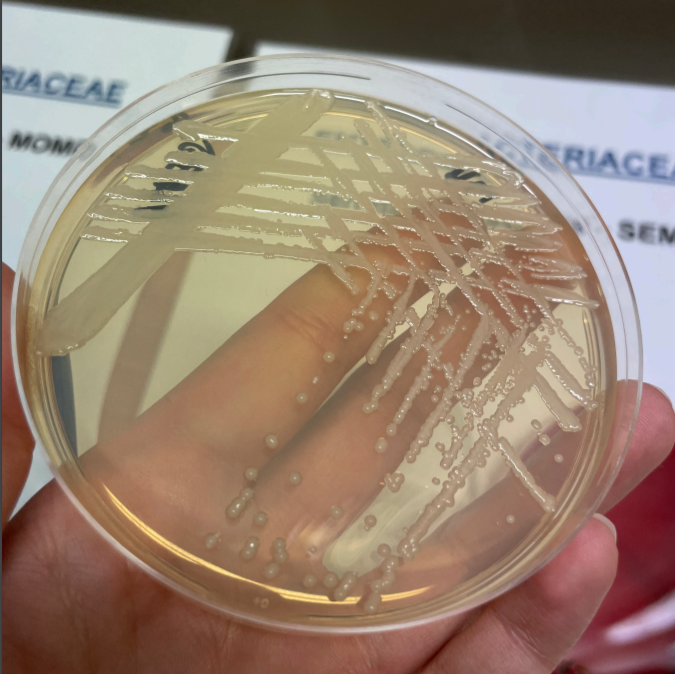

Serratia Bizio, 1823 è un genere di batteri Gram-negativi della famiglia Yersiniaceae. Di frequente presente nell'ambiente, soprattutto nel suolo, questi enterobatteri sviluppano di solito colonie di un colore rosso acceso. Sono patogeni opportunisti e sviluppano nell'uomo infezioni resistenti a molti antibiotici.
Alcuni ceppi di Serratia, in particolare il ceppo Serratia E-15, producono un particolare enzima dotato di attività proteolitica, serrapeptasi, che ha trovato impiego anche come farmaco.
Note
Altri progetti
- Wikimedia Commons contiene immagini o altri file su Serratia
- Wikispecies contiene informazioni su Serratia